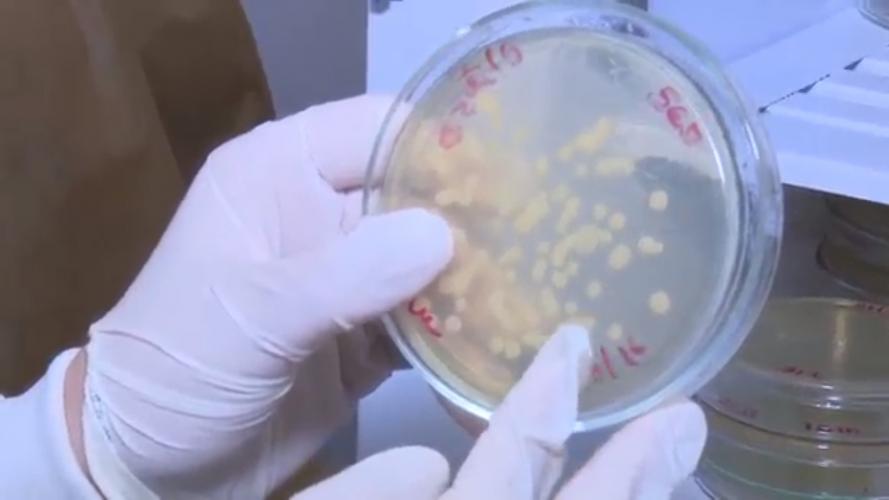
.

Parceria entre Unicentro e Secretaria de Saúde possibilita atendimento completo à mulher guarapuavana 19/12/2019 - 09:07
Atenção especial à saúde da mulher na Unidade Básica de Saúde da Vila Carli. Quem fez os exames preventivos do câncer de colo, recebeu um diagnóstico completo. Esse atendimento foi possível graças a uma parceria estabelecida entre a Unicentro e a Secretaria Municipal de Saúde. O projeto, como conta o coordenador das atividades, professor Marcos Ereno Auler, permitiu que além do papanicolau, as pacientes também realizassem o exame microbiológico.
“A gente faz avaliação da microbiota da mulher para ver se a mulher tem defesa na sua microbiota, para ver se ela tem infecção por bactéria ou por fungos. Esse exame complementa bastante no sentido de avaliar o processo inflamatório, o processo infeccioso e, além do que, a paciente vai ser beneficiada com o laudo do exame citopatológico para ver se ela tem uma alteração celular”, explica Marcos.
O projeto iniciou em 2017 e foi finalizado no último mês. Nesse período, foram atendidas de mais 700 mulheres. Primeiro, as pacientes passavam por uma entrevista com a equipe do projeto. Com as informações e a autorização para realizar o exame microbiológico, elas eram encaminhadas para a sala de coleta. “\Nós fazemos a coleta aqui do citopatológico, em parceria com a Unicentro, que faz a coleta do exame de secreção vaginal e o citopatológico é encaminhado para a Clínica da Mulher, de onde ele vai para o laboratório terceirizado que realiza, então, a análise desses exames e o de secreção vaginal, que os alunos da Unicentro fazem a coleta, são enviados, então, junto com eles, para o laboratório da Unicentro”, detalha a coordenadora da UBS, Fabíola Assis.
Adriana Santos foi uma das pacientes atendidas pelo projeto. A qualidade do atendimento e as análises detalhadas chamaram a atenção da professora, que logo que ficou sabendo do projeto, quis marcar um horário para realizar os exames. “Eu achei bem interessante porque, muitas vezes, a gente acaba sem saber realmente o que que tem assim. É muito importante. A gente precisa se prevenir, precisa se cuidar”.
O laudo é entregue para a paciente depois de 20 dias. Nesse período, para garantir a qualidade dos procedimentos e os resultados, as amostras coletadas eram encaminhadas para os laboratórios da Unicentro para serem avaliadas em diferentes métodos. “Essas análises são feitas no Laboratório-Escola e no Laboratório de Micologia Clínica, do Departamento de Farmácia da Unicentro. Um mutirão grande para poder auxiliar e para trazer essa parceria com a comunidade, mostrar a importância da Universidade, da Unicentro inserida na região aqui, levando saúde às pessoas”, diz Marcos. A professora Any do Castro, que também participa do projeto, completa: “Esse material todo que a gente consegue coletar da paciente, a gente consegue observar diversos microrganismos presentes, que podem estar correlacionados com a clínica da paciente”.
O trabalho realizado durante os dois anos é motivo de alegria. Agora, a expectativa é poder, em breve, voltar a realizar os exames. “”A comunidade se mostrou muito interessada, está nos cobrando para que a gente continue e a gente espera conseguir dar sequência nesse projeto da Unicentro com a Prefeitura Municipal, a Secretaria de Saúde, para a gente ver se consegue dar essa atenção para esse público, para essas pacientes que tanto precisam”, ressalta o professor Marcos Auler.